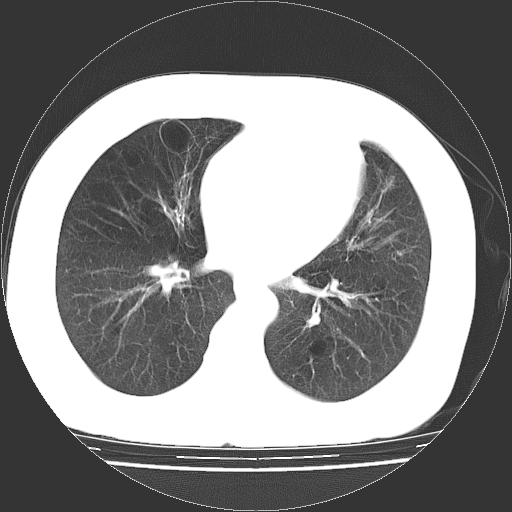

医影在线
标题: CT13141:女,70岁,咳嗽、胸闷半个月。 [打印本页]
作者: wpf 时间: 2008-4-29 06:18
标题: CT13141:女,70岁,咳嗽、胸闷半个月。
女,70岁,咳嗽、胸闷半个月。纵隔窗未见异常,未上传。

[本贴已被 jiajie 于 2008-4-29 6:08:35 修改过]
作者: chenaide 时间: 2008-4-29 07:01
慢支炎、肺气肿征,双肺多发肺大泡
作者: 37度 时间: 2008-4-29 07:24
小叶中心型肺气肿并多个肺大泡形成。
作者: liuyue 时间: 2008-4-29 07:26
小叶中心性肺气肿及间隔旁肺气肿.(多与吸烟有关)
作者: xuhuihong 时间: 2008-4-29 08:54
小叶中心型肺气肿并多个肺大泡形成
作者: yangyudong333 时间: 2008-4-29 12:55
小叶中心型肺气肿并多个肺大泡形成
作者: qc80012345 时间: 2008-4-29 13:16
小叶中心型肺气肿并多个肺大泡形成
作者: xyd820 时间: 2008-4-29 14:38
双肺肺气肿并多发肺大泡
作者: yytbzjw 时间: 2008-4-29 15:51
标题: 回复:ct13141:女,70岁,咳嗽、胸闷半个月。
以下是引用xuhuihong在2008-4-29 0:54:00的发言:[br]小叶中心型肺气肿并多个肺大泡形成
作者: zsl6918 时间: 2008-4-29 16:10
多发肺大泡
作者: 深泽交通 时间: 2008-4-29 16:23
zhi chi
作者: dyqct 时间: 2008-4-29 16:50
慢性支气管炎合并小叶中心性肺气肿及间隔旁肺气肿.(多与吸烟有关)。
作者: 宇宙CT 时间: 2008-4-29 17:05
小叶中心性肺气肿及间隔旁肺气肿.(多与吸烟有关)
作者: 杀毒软件 时间: 2008-4-29 17:18
多发肺大泡
作者: mzh123 时间: 2008-4-29 19:28
标题: 回复:ct13141:女,70岁,咳嗽、胸闷半个月。
以下是引用chenaide在2008-4-28 23:01:00的发言:[br]慢支炎、肺气肿征,双肺多发肺大泡
作者: zjzjr 时间: 2008-4-29 22:02
慢性支气管炎合并小叶中心性肺气肿,多发性肺大泡
作者: xulianj 时间: 2008-4-29 23:43
小叶中心型肺气肿并多个肺大泡形成 。
作者: 光影相伴 时间: 2008-4-29 23:59
1.小叶中心型肺气肿。
2.左肺下舌段感染性病变。
作者: jinguoji 时间: 2008-4-30 01:50
慢性支气管炎并小叶中心性肺气肿及间隔旁肺气肿.(多与吸烟有关)。
作者: 随光逐影 时间: 2008-4-30 02:03
双肺多发肺大泡。
作者: zhw974247 时间: 2008-4-30 02:12
标题: 回复
肺大疱的壁甚薄,由肺泡的扁平上皮细胞组成,也可能仅为纤维性膜。可与多种肺气肿并存,常见于间隔旁侧或细叶旁肺气肿,可伴有碳末沉着,如煤矿工人尘肺,或不伴有碳末沉着,如瘢痕组织肺气肿。根据病理形态将肺大疱分为三种类型。
ⅰ型:狭颈肺大疱。突出于肺表面,并有一狭带与肺相连。因为支气管瘢痕组织形成的活瓣性阻塞,肺大疱体积增大系由于肺泡侧支通气和气体滞留。ⅰ型肺大疱壁薄,常由胸膜和结缔组织形成,多发生于中叶或舌叶,也常见于肺上叶,可能由于该部位胸腔负压大,常规胸片即可发现肺大疱的存在。
ⅱ型:宽基底部表浅肺大疱。位于肺表层,在脏层胸膜与气肿性肺组织之间。肺大疱腔内可见结缔组织间隔,但它不构成肺大疱的壁,可见于肺的任何部位。
ⅲ型:宽基底部深位肺大疱。结构与ⅱ型相似,但部位较深,周围均为气肿性肺组织,肺大疱可伸展至肺门,可见于任何肺叶。
当肺大疱体积增大时,周围肺组织受压迫并引起肺脏移位。受压肺组织在x线胸片上,表现为肺大疱周围密度增高阴影。以上三型均见于慢性支气管炎。小叶中心型肺气肿不并发肺大疱。下叶肺大疱常见于有并发症的煤矿工人尘肺和融合性矽肺。
[本贴已被 zhw974247 于 2008-4-29 18:18:54 修改过]
作者: hjk 时间: 2008-4-30 02:27
支持
作者: 拾荒者 时间: 2008-4-30 05:42
小叶中心型肺气肿并多个肺大泡形成 。
作者: hou-wg 时间: 2008-4-30 05:50
多发肺大泡
小叶中心型肺气肿
| 欢迎光临 医影在线 (http://bbs.radida.com/bbs/) |
Powered by Discuz! X3.2 |